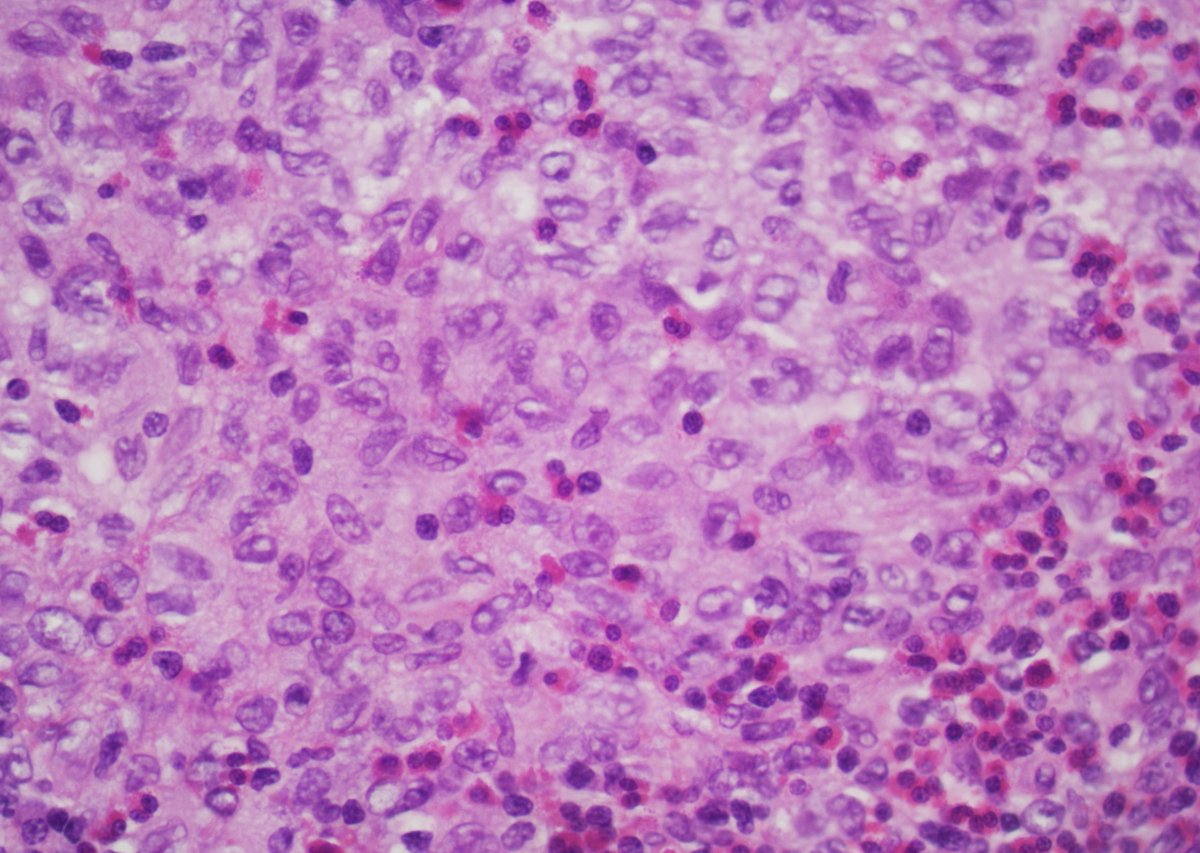
GuannanTiffany's tweet image. 🧩 Bladder riddle

Unusual location.
Think of something more common in children.
What’s the diagnosis? 🤔

#DxMindMap #BladderTumor #GUPath #PathTwitter

#gupath search results
🔬📸 Seminal Vesicle Epithelium, with golden yellow nuggets 🟡 of Lipofuscin Pigment ~ #GUpath #Pathology #Histology #PathArt

Great case from @TingZhaoPathdoc from @MGHPathology @MGBpathology for @IntSocUropath case of the month! The current #GUPath fellow, catch her soon as new faculty @BIDMCpath!
Go to isupweb.net to see more of the case! #gupath #pathtwitter #ISUPCOTM Authors: Authors: Ting Zhao, MD, Peter M. Sadow, MD, PhD: Massachusetts General Hospital, Harvard Medical School, Boston, MA, USA @TingZhaoPathdoc @PathDocBoston

🔬📸 Papillary Renal Cell Carcinoma ~ Tubular architecture in a papillary RCC ~ #GUpath #Pathology #Kidney #PathArt

🔬📷 "Papillary and Thyroidized" ~ At the edge of a papillary renal cell carcinoma (right half of image) next to background renal parenchyma (left half of image) in an end stage kidney ~ #GUpath #RenalPath #Kidney #Pathology #PathArt

🔬📸 "Polka Dots and Bubbles" 🔵🫧⚪️ ~ Glycogenated cells in a Low Grade Papillary Urothelial Carcinoma ~ #GUpath #Pathology #PathArt

🔬📷 A big plump raisin! 🍇 ~ Nucleus with "raisinoid" features in a Chromophobe RCC ~ #GUpath #Pathology #PathArt

🔬 Can you make the diagnosis at 2x...? Incidental Renal Nodule (found at the time of autopsy). #GUpath #Pathology #Kidney #RenalPath #PathResidents

It’s time for a #PathQuiz 🧐 Test your knowledge on #GUPath below 💡 can you get all 10? #PathX #histopath /🧵

This is not a complicated #GUPath case. These prostate glands are "too many, too small, and too crowded" to be benign. They also "cross the street" (i.e. traverse the entire width of the bx core). Other soft signs of PCA which, imo, are very helpful are seen here: crystals &




Umbrella Cells of Bladder They can stretch when distended with urine On Urine Cyto, they can look quite large and be multinucleated #pathx #gupath #pathology #histology #medstudent

A brief summary on the carcinoma prostate. Hope this may help! #prostate #GUpath #residency #pathology #Gleason #ISUP #GUPS

🧩 Bladder riddle Unusual location. Think of something more common in children. What’s the diagnosis? 🤔 #DxMindMap #BladderTumor #GUPath #PathTwitter

Incredible #GUpath opportunity!
🚨Now accepting applications! 🚨 The Genitourinary Pathology Fellowship Program at @brownpathology and @BrownUnivHealth has openings for July 2026 and July 2027. Come hone your diagnostic skills at a leading, high volume academic center, where you will have tremendous




Osseous metaplasia in clear cell RCC #GUpath ⏩Rare in RCC ⏩Metaplastic, benign‑appearing bone formation, with or without marrow elements, within otherwise typical RCC ⏩Proposed mechanisms: response to tissue ischemia; induction by bone morphogenetic protein‑2 (BMP‑2) (PMID:
while we've had concurrent digital avail for past several years for routine🔬cases, only recently have we been able to have digital scans for the whole mount prostatectomies we do nice #GUpath #grosspath correlation of prostate cancer #makingprostatepathfunagain




The art of grossing. A 75 yo man with urgency and hematuria. Radical Prostatectomy. Final Dx.Acinar Adenocarcinoma 4+4=8 (GG:4).Volume 60%. #pathologists#pathresidents #GUpath

#PathQuiz 🔬🧬 A) Chromophobe RCC B) Oncocytoma C) SDH-Deficient RCC D) Low-grade Oncocytic Tumor #Pathology #GUPath #KidneyPath

#PathQuiz 🔬 A) Chromophobe RCC B) Oncocytoma C) SDH-Deficient RCC D) Eosinophilic Solid and Cystic RCC #Pathology #GUPath

#PathQuiz 🔬 A) Urothelial Papilloma B) Papillary Urothelial Neoplasm of Low Malignant Potential C) Non-invasive Papillary Urothelial Carcinoma, High-Grade D) Non-invasive Papillary Urothelial Carcinoma, Low-Grade #Pathology #GUPath #BladderPath


#GUpath nephrectomy: Dx: clear cell papillary renal cell tumor (I wish they'd named it clear cell TUBULOPAPILLARY renal tumor to emphasize morph!) here,😍example of "shark smile" (tubulopapillary morph)🔬, as some cases lack prominent "reverse-apical" nuclei!




🧩 Bloody Bladder When signing out this lesion, what clinical question comes to mind? 👨 65-year-old man • Prior prostate adenocarcinoma? 👩 45-year-old woman • Prior cervical carcinoma? not always. So… what’s the diagnosis? 🤔 #DxMindMap #BladderTumor #PathTwitter #JHUPath



A beautiful example of clonal origin with lineage divergence #gupath @IntSocUropath @GU_Path_Society
Carcinoma o… qualcosa di più insidioso? 👀 Quando un angiosarcoma epitelioide della vescica si traveste da carcinoma uroteliale invasivo e infiltra il detrusore: il vero maestro del mimetismo in istopatologia. PMID: 25929352 #GUpath #DiagnosticChallenge @IntSocUropath

#GUpath TURBT: small cell carcinoma ➕concomitant urothelial carcinoma in situ curiously: both elements share aberrant loss of Rb1




Some myoid gonadal stromal tumors may have CD34 immunoexpression (C, F), in addition to S100 (B, E). #GUpath #pathology

Something went wrong.
Something went wrong.
United States Trends
- 1. Happy 420 N/A
- 2. AJ Brown N/A
- 3. #BuschAppleSweepstakes N/A
- 4. Sonny Gray N/A
- 5. Brandon Aubrey N/A
- 6. Discovery N/A
- 7. The Atlantic N/A
- 8. Boutte N/A
- 9. Jack Flaherty N/A
- 10. #MondayMotivation N/A
- 11. Boston Marathon N/A
- 12. Practical Magic 2 N/A
- 13. #holoSerendipity N/A
- 14. Rodgers N/A
- 15. John Korir N/A
- 16. Jim Ryan N/A
- 17. Dasani N/A
- 18. FBI Director Kash Patel N/A
- 19. Sharon Lokedi N/A
- 20. Kimi K2 N/A

























































